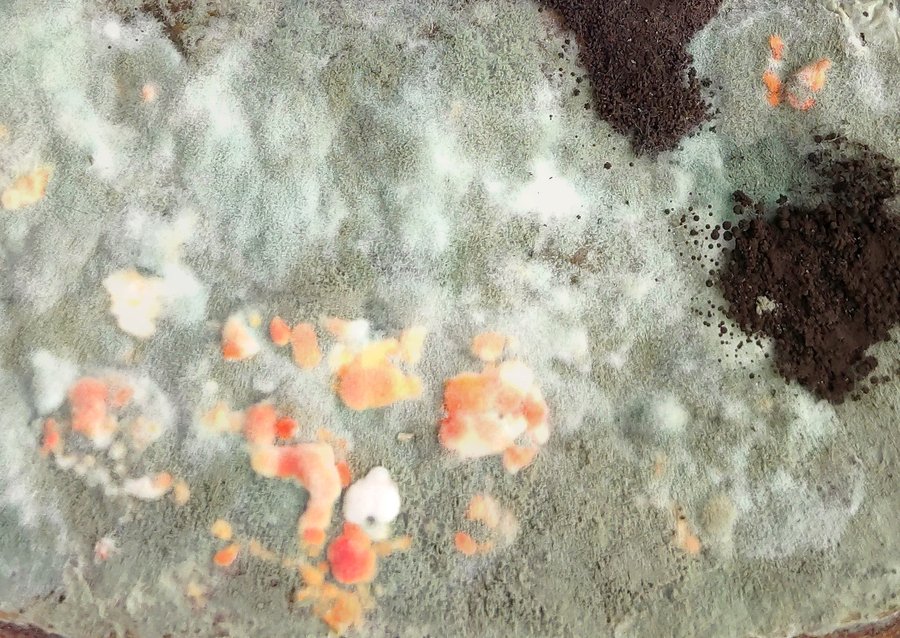
big

Я обычный человек из Болгарии. В детстве мне нравилось быть в поле и на природе, и собирать с земли всевозможные фрукты и овощи. Мой отец фермер, поэтому и у нас всегда дома были свежие фрукты и овощи, а моя мама профессиональный повар и она все эти продукты вкусно готовила для меня и моего брата. Дома мы никогда не позволяем продуктам плесневеть, поэтому я никогда в жизни не видел плесени на еде, но все резко изменилось, когда я стал жить в Москве в общежитии.
Я никогда раньше не видел такого отношения к еде, и было очень интересно каждый день открывать холодильник и смотреть, на какой стадии находится их продукция в процессе рост плесени. В это время они меняют свой вид и становятся картинами, на которые можно смотреть часами. Любуясь этими картинами, можно даже забыть о первоначальной форме продукта и о том, какой он был на самом деле.
Именно мой опыт в общежитии вдохновил и побудил меня провести это исследование. С его помощью я хочу показать этот процесс от свежего состояния продуктов, какими мы их привыкли видеть, до заплесневелого состояния, где истинный вид продукта теряется и он становится абстрактной пейзаж.

Технология создания
Технические особенности
Focus stacking/Фокус стекинг
все фотографии сняты телефоном Xiaomi Mi Note 10 Lite